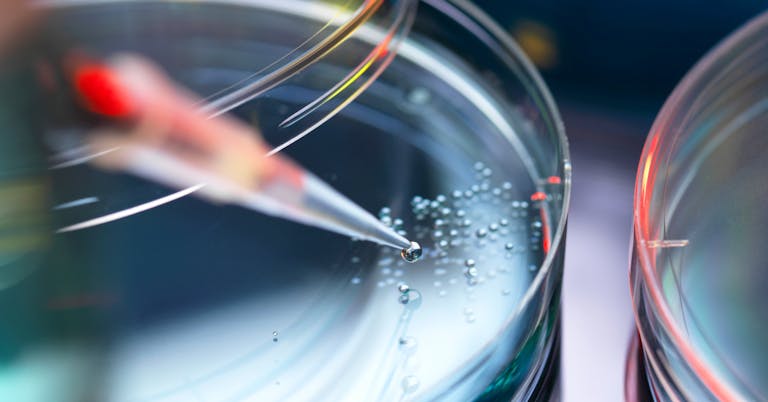
petri dish

Medtronic, a leading healthcare technology company, faced challenges in preparing its workforce for the future. Degree requirements excluded qualified candidates, tuition costs kept education out of reach for others, and limited career pathways restricted employee growth.
To address these challenges, Medtronic partnered with InStride to launch Medtronic Advancement Pathways and Skill-building (MAPS), a debt-free education program that provides full tuition coverage at partner schools and aligns learning to real job opportunities within the business.
The results:
- 3,000+ employees enrolled or completed learning programs
- 20% of employee learners promoted within one year
- $13M in retention savings with a 93% retention rate
This case study highlights how Medtronic:
- Replaced degree requirements with skills- and experience-based hiring
- Launched debt-free education to expand access to career growth
- Strengthened its talent pipeline while delivering ROI
Looking for quick takeaways? Grab a summary of these results.
Want to do a deeper dive? Download the full case study here.